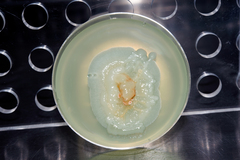
Thyronectria

Thyronectria: taxon details and analytics
- Domain
- Kingdom
- Fungi
- Phylum
- Ascomycota
- Class
- Sordariomycetes
- Order
- Hypocreales
- Family
- Nectriaceae
- Genus
- Thyronectria
- Species
- Scientific Name
- Thyronectria
Summary description from Wikipedia:
Images from inaturalist.org observations:
We recommend you sign up for this excellent, free service.
Parent Taxon
Sibling Taxa
- Acremoniopsis
- Albonectria
- Allantonectria
- Aquanectria
- Atractium
- Bisifusarium
- Calonectria
- Calostilbe
- Chaetopsina
- Ciliciopodium
- Corallomycetella
- Corallonectria
- Corinectria
- Cosmospora
- Cosmosporella
- Cyanonectria
- Cylindrium
- Cylindrocladiella
- Cylindromonium
- Dialonectria
- Fusarium
- Fusicolla
- Geejayessia
- Gliocephalotrichum
- Gliocladiopsis
- Ilyonectria
- Macroconia
- Mariannaea
- Microcera
- Murinectria
- Nalanthamala
- Nectria
- Neocosmospora
- Neonectria
- Payosphaeria
- Penicillifer
- Pseudocosmospora
- Pseudonectria
- Rectifusarium
- Sarcopodium
- Stylonectria
- Thelonectria
- Thyronectria
- Xenoacremonium
- Xenonectriella
Child Taxa
- Thyronectria abieticola
- Thyronectria aquifolii
- Thyronectria asturiensis
- Thyronectria atrobrunnea
- Thyronectria aurigera
- Thyronectria austroamericana
- Thyronectria balsamea
- Thyronectria berberidis
- Thyronectria berolinensis
- Thyronectria boothii
- Thyronectria caraganae
- Thyronectria caudata
- Thyronectria chlorinella
- Thyronectria chrysogramma
- Thyronectria citri
- Thyronectria clavatispora
- Thyronectria concentrica
- Thyronectria coryli
- Thyronectria cucurbitula
- Thyronectria giennensis
- Thyronectria ilicicola
- Thyronectria lamyi
- Thyronectria lonicerae
- Thyronectria obscura
- Thyronectria okinawensis
- Thyronectria orientalis
- Thyronectria pinicola
- Thyronectria pistaciae
- Thyronectria pseudomissouriensis
- Thyronectria pyrrhochlora
- Thyronectria quercicola
- Thyronectria rhodochlora
- Thyronectria rosellinii
- Thyronectria roseovirens
- Thyronectria rubicarpa
- Thyronectria sinensis
- Thyronectria sinopica
- Thyronectria sophorae
- Thyronectria sphaerospora
- Thyronectria strobi
- Thyronectria ulmi
- Thyronectria virens
- Thyronectria yuccae
- Thyronectria zangii
- Thyronectria zanthoxyli